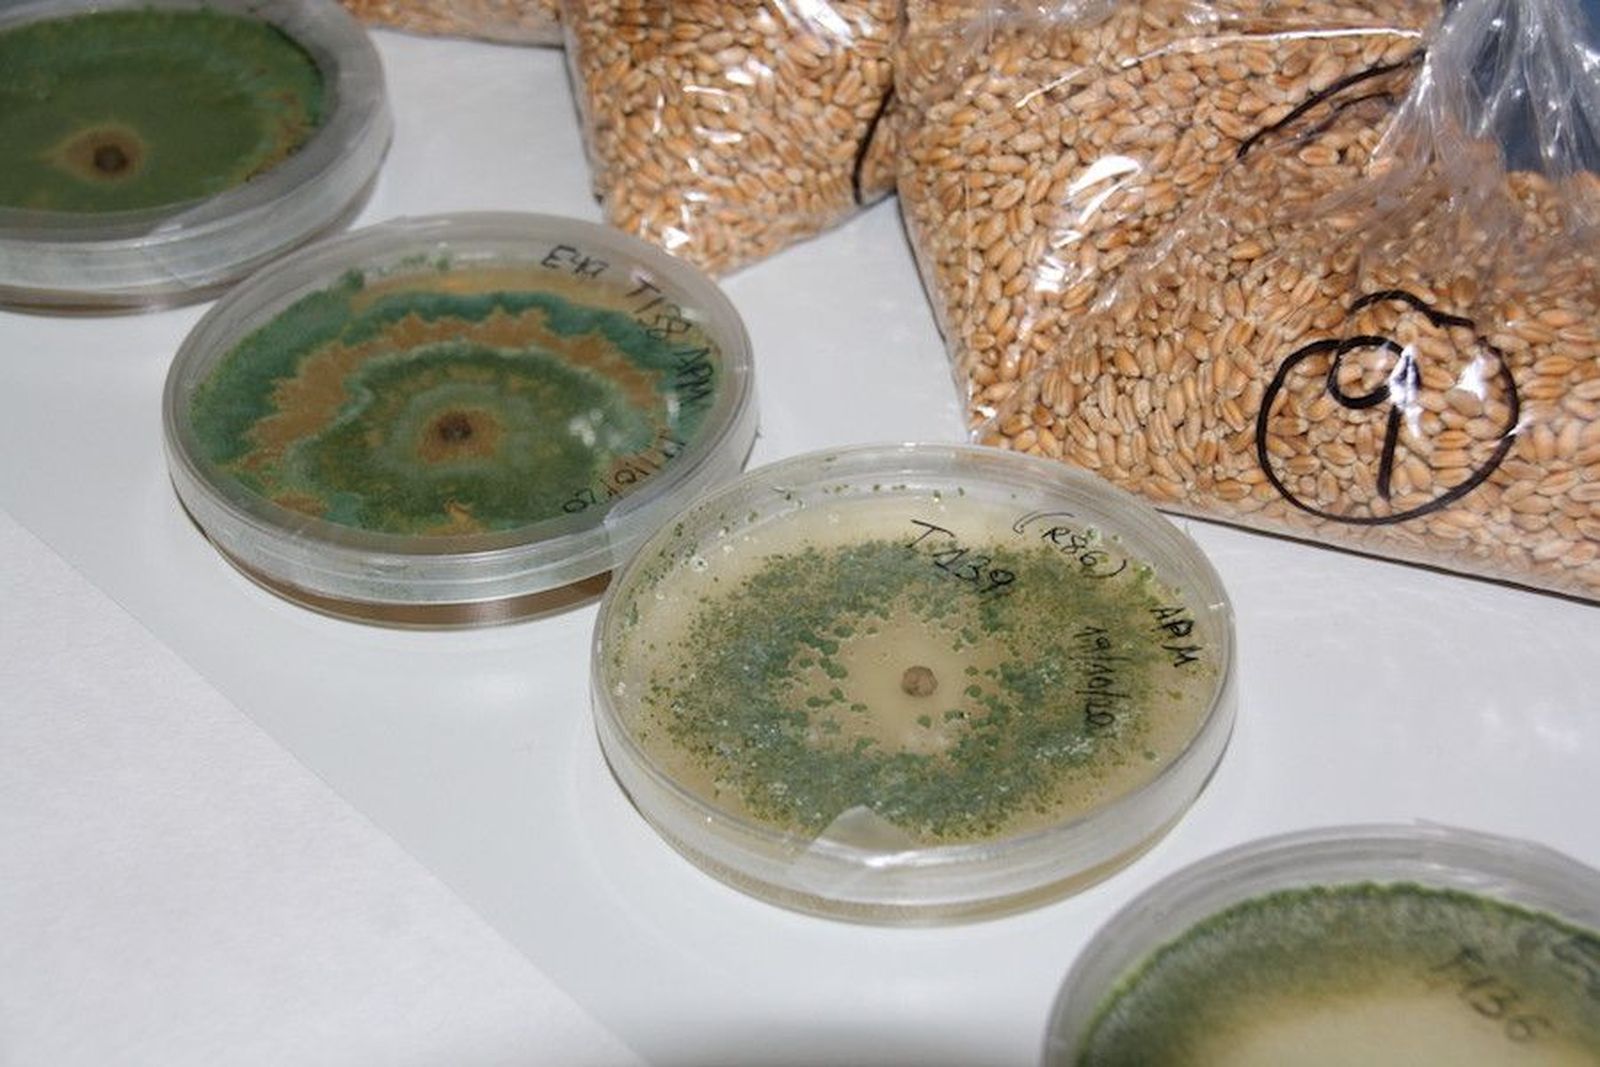
49029

Seis grupos de investigación de la USAL comienzan a diseñar la agricultura del futuro
La Unidad de Excelencia de Producción Agrícola y Medio Ambiente (Agrienvironment) va a poner en marcha cuatro nuevos proyectos financiados por la Junta de Castilla y León

La Unidad de Excelencia de Producción Agrícola y Medio Ambiente (Agrienvironment), que agrupa a seis grupos de investigación de la Universidad de Salamanca, va a poner en marcha cuatro nuevos proyectos financiados por la Junta de Castilla y León, publica la Agencia Dicyt.
Estas iniciativas se traducirán en innovaciones relacionadas con la viticultura, el estudio de la humedad del suelo, la biología translacional y los microorganismos relacionados con sequías e inundaciones, la utilización de hongos para mejorar el cultivo de la colza y proteger el castaño; y finalmente, el análisis de aguas en la lucha contra la pandemia de COVID-19.
Agrienvironment logra más de 870.000 euros en el marco de la convocatoria regional de subvenciones del programa de apoyo a proyectos de investigación cofinanciadas por el Fondo Europeo de Desarrollo Regional (FEDER). De esta forma, esta Unidad de Excelencia se consolida como un referente en la mejora de la agricultura en la comunidad. “Va a ser un gran impulso desde ahora hasta 2023”, asegura en declaraciones a DiCYT Óscar Lorenzo, director de Agrienvironment, que se felicita especialmente porque supondrá crear empleo, ya que los proyectos permitirán incorporar a seis investigadores posdoctorales que van a estar contratados durante dos años.
La uva y el vino
El Grupo de Investigación en Polifenoles se centrará en un sector del máximo interés para la economía de Castilla y León: la uva y el vino. Desde hace décadas estudia los compuestos fenólicos o polifenoles, sustancias que se encuentran en casi todos los productos de origen vegetal. Diferentes trabajos los relacionan con la calidad, las características sensoriales de los alimentos y también con la salud humana, ya que pueden ejercer cierta protección frente a enfermedades cardiovasculares y neurodegenerativas, explica Celestino Santos Buelga.
Como consecuencia del cambio climático, se está desajustando la maduración de la uva (en cuanto a acumulación de azúcares que después permiten la fermentación y, como consecuencia, el alcohol en el vino) y el proceso de acumulación de compuestos fenólicos o madurez fenólica. La vendimia en el momento de madurez fenólica adecuado para obtener un vino de calidad sensorial elevada en ocasiones supone dejar que la uva alcance concentraciones demasiado elevadas de azúcar y, por tanto, que la graduación alcohólica del vino aumente.

El proyecto consiste en estudiar cómo controlar la madurez de las uvas para que tengan un contenido adecuado de sustancias fenólicas sin llegar a alcanzar un grado alcohólico excesivo. Si no fuera posible, una opción sería corregirlo en los vinos, estudiando los mecanismos moleculares que explican la sensación de astringencia en la boca o el color. Además, se van a estudiar mecanismos relacionados con los efectos beneficiosos de los polifenoles en el organismo, en particular en relación con la prevención del deterioro cognitivo.
Será una investigación básica, con ensayos ‘in vitro’ y en el gusano ‘Caenorhabditis elegans’, que se utiliza como modelo porque pueden reproducir enfermedades como el alzhéimer. Para ello, utilizarán subproductos que sobran tras el proceso de vinificación y que, de esta forma, ganarían valor añadido y podrían utilizarse en la formulación de alimentos funcionales. El proyecto cuenta con la colaboración de Bodegas La Horra y Bodegas Matarromera para su realización.
La humedad del suelo
Por su parte, el Grupo de Recursos Hídricos estudiará la influencia de la humedad del suelo en la productividad de los cereales. Este factor es determinante para el rendimiento de los cultivos, pero hasta ahora solo se ha estudiado de forma indirecta a partir de variables climáticas, como las lluvias o la temperatura. Sin embargo, en la actualidad los datos que proporcionan los satélites de la NASA y de la Agencia Espacial Europea (ESA), junto con la modelización, ya permiten obtener información sobre la humedad del suelo en cualquier punto del planeta con una gran precisión. “
Nosotros ya tenemos bases de datos que abarcan 40 años y podemos analizar cómo influye el contenido en agua del suelo en la producción de trigo y cebada”, explica el investigador José Martínez. El proyecto se centra en Castilla y León, pero incluye un análisis comparativo con otras dos regiones líderes en producción de cereales, Castilla La Mancha y Baviera (Alemania).
Conocer la influencia de la humedad del suelo en los cultivos, permitirá contrastar esta información con otros factores medioambientales (temperatura, precipitación, evaporación, etc…) y generar modelos predictivos del rendimiento. “Serán de gran utilidad para agricultores, gestores o empresas”, apunta el investigador. De hecho, el proyecto se desarrollará en colaboración con la cooperativa ACOR y con el Grupo AN, que incluye 160 cooperativas y es el principal comercializador de cereales de España.
Sequía e inundaciones
El Grupo de Fisiología y Señalización Hormonal en Plantas ha obtenido financiación para estudiar la protección de los cultivos frente al estrés hídrico y la hipoxia (falta de oxígeno), es decir, tanto sequía como inundaciones, dos problemas exacerbados por el cambio climático.
El proyecto tiene una vertiente de análisis genético, para ver qué genes ayudan a las plantas en estas situaciones y su edición a través de la tecnología CRISPR Cas, y la interacción con otros organismos, como bacterias del suelo, que también pueden ser beneficiosos. Para ello contarán con la colaboración de investigadores de prestigio como el Dr. Roberto Solano, del Centro Nacional de Biotecnología (CNB-CSIC), y el Dr. Miguel Ángel Blázquez, del Instituto de Biología Molecular y Celular de Plantas (IBMCP, CSIC-UPV).
Los estudios se llevarán a cabo en dos plantas modelo, ‘Arabidopsis thaliana’ y ‘Marchantia polymorpha’. Esta última es “especialmente interesante desde el punto de vista evolutivo, porque tiene muy baja redundancia y prácticamente un gen para cada función”, explica el investigador Óscar Lorenzo. Esto significa que cualquier modificación que puedan realizar los científicos en su genoma tiene unos resultados muy evidentes, a diferencia de otras, en las que varios genes pueden llevar a cabo la misma función. No obstante, las conclusiones que obtengan se pueden extrapolar a plantas de interés agronómico, en particular cereales y gramíneas del género ‘Lolium’.
El grupo colabora también con la empresa de semillas Cecosa, que porporciona importantes herramientas en cultivos de interés agronómico para la región y el Instituto Biomar de León, que cuenta con una gran colección de microorganismos. Estudiarlos, en particular las bacterias endófitas –las que se encuentran en el interior de las plantas– revela “propiedades beneficiosas para procesos de crecimiento y desarrollo que aún no se han estudiado en profundidad”, asegura el investigador. En este caso, los microorganismos pueden ayudar a los cultivos a sobrevivir en situaciones de estrés provocadas por la falta o el exceso de agua.
Hongos como agente de biocontrol
Otro proyecto relacionado con la interacción entre plantas y microorganismos es el que lidera Enrique Monte, del Grupo de Fitopatología y Control Biológico. En concreto, este equipo trabaja con ‘Trichoderma’, un hongo que tiene propiedades como agente de control biológico y que se utiliza en agricultura por sus propiedades biofertilizantes y para proteger a las plantas frente a patógenos. “Este hongo hace dos cosas, estimula el crecimiento de la planta y la ayuda a defenderse”, afirma Monte. En el nuevo estudio, analizarán un gen de ‘Trichoderma’ que, introducido en colza, hace que estas plantas tengan micorrizas, una asociación entre hongo y raíz.
“Las micorrizas colonizan cualquier planta menos las brasicáceas, porque tienen unas toxinas que lo evitan, pero nosotros lo hemos logrado con ‘Trichoderma’”, explica el investigador. De esta forma, se obtiene una colza transgénica que aumenta la producción gracias a las micorrizas, que ayudan a las plantas a movilizar fósforo del suelo, un promotor del crecimiento. Es una especie de biofertilización beneficiosa para la planta, pero a la vez contribuye a bajar la toxicidad de la colza.

“Del aceite de colza hay que eliminar los glucosinolatos, porque son tóxicos para el ser humano, pero este tiene menos toxicidad, así que este proyecto aumenta la producción y abarata costes de procesamiento, una gran ventaja biotecnológica”, subraya. Ahora, esta nueva financiación ayudará a explicar los mecanismos moleculares que explican el proceso porque los científicos piensan que actuando sobre genes concretos podrían lograr los mismos efectos en una colza no transgénica.
Otra parte del proyecto es el estudio de un nuevo mecanismo de acción de ‘Trichoderma’. El Grupo de Fitopatología y Control Biológico ha descubierto que este hongo tiene virus. “Al igual que nosotros tenemos virus, también hay micovirus que atacan a los hongos y, en este caso, hemos visto que tiene uno de otra especie de hongo que no le correspondería.
Lo interesante es que hemos encontrado un micovirus que afecta al principal patógeno de los castaños, llamado ‘Cryphonectria’, de manera que en presencia de ese virus no produce daño al árbol”. De esta forma, ‘Trichoderma’ puede transmitir el virus al patógeno del castaño y convertirse en un agente de control biológico para proteger a los castaños sin pesticidas.
Estudio sobre COVID-19
El equipo de Monte ha incluido una tercera investigación en el proyecto financiado por la Junta, que también está relacionada con virus, pero en este caso con el más famoso de la actualidad y que no tiene que ver con hongos ni plantas, sino con el ser humano: el coronavirus. En los últimos meses ha analizado las aguas residuales de Salamanca como indicador de la incidencia de COVID-19 y ha desarrollado un protocolo para hacerlo. Aunque el SARS-CoV-2 no sobrevive, quedan restos de su ARN que se pueden detectar y convertirse en datos útiles para la gestión sanitaria. Ahora quieren establecer cuáles son los horarios y los puntos concretos de toma de muestras más interesantes en diferentes poblaciones de Castilla y León.
También te puede interesar
Lo último








